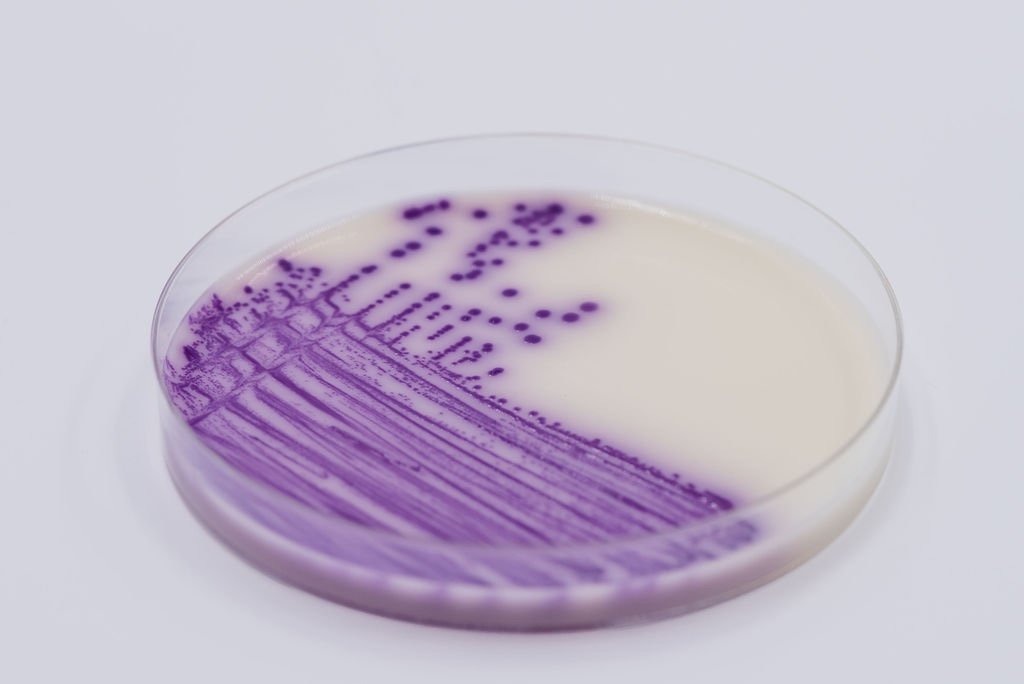

Description
Thermo Scientific offers a comprehensive portfolio of microbial culture solutions designed to support laboratory workflows across various industries, including food microbiology, clinical diagnostics, pharmaceutical testing, and veterinary microbiology. With over 100 years of expertise, the range encompasses everything from high-quality dehydrated culture media to convenient prepared plates and innovative atmosphere generation systems. Their dehydrated culture media (DCM) includes a vast selection of high-quality base products, supplements, and animal-free formulations, all rigorously tested to ensure performance consistency. For laboratories looking to optimize efficiency, the prepared culture media options, such as the automation-compatible SmartPlate and specialized bi-plates, help reduce labor costs and streamline specimen processing. Additionally, the Atmosphere Generation Systems provide the precise anaerobic, microaerophilic, or CO2 conditions necessary for specialized organism growth while maximizing incubation space. By integrating solutions like the Tailored Delivery Solution (TDS) and QuickBag enrichment media, laboratories can minimize waste and improve ergonomics. These products are backed by a culture of trust and quality, ensuring that every sample is handled with the highest standards of accuracy and reliability. Whether you are performing routine quality control or identifying complex infections, these microbial culture systems provide the tools needed to safeguard product quality and patient health.
Extensive selection of high-quality dehydrated culture media and supplements
Ready-to-use prepared culture media plates for reduced labor and consistent results
Innovative atmosphere generation systems for anaerobic and microaerophilic growth
Automation-compatible SmartPlate designs for optimized specimen processing
Animal-free media formulations to support specialized pharmaceutical requirements
Tailored Delivery Solution to minimize cardboard waste and improve stock management
QuickBag and FitBag formats for simplified enrichment media preparation
Comprehensive quality control products including Culti-Loops for safe culture preparation
Rigorous quality testing throughout the manufacturing process for reliable performance
Specialized bi-plates to increase productivity and reduce laboratory costs